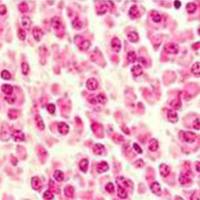
IHC染色

万千商家帮你免费找货
0 人在求购买到急需产品
- 详细信息
- 技术资料
- 提供商:
锐博生物
- 服务名称:
细胞健康与毒性
锐博生物可以提供细胞健康与毒性分析与筛选:
1、活/死细胞检测
2、细胞活力/生存能力检测
3、线粒体健康
4、细胞凋亡-Caspase 分析
5、细胞凋亡- Tunel分析
6、微核分析
7、细胞自噬
8、细胞毒性
9、细胞吞噬ADCP
10、细胞内吞程度分析
11、ADC/抗体毒性
12、中药毒性
13、干细胞毒性
14、钙离子
15、氧分子和活性氧簇
16、DNA损伤(与修复)
服务优势
1、高效快速:实验时间从几个月数天缩短至几个小时甚至几分钟
2、准确强大:通过多荧光标记、系统快速捕捉、高分辨率成像和强大软件分析
3、操作简单:全程自动化
项目举例
hESC来源心机细胞检测药物心脏毒性(IN Cell平台)

细胞毒性分析(IN Cell平台)
细胞凋亡分析


活细胞/ 死细胞分析(TTP Acumen平台)

MTS抑制基因的siRNA干扰对细胞活性的影响

利用高内涵高通量筛选平台检测各种药物的细胞毒性(TTP Acumen平台)

了解相关产品或服务信息请登录锐博生物官网 https://www.ribobio.com/product-and-service/high-content-cellular-imaging-detection-function-assays-and-screening-service/cell-health-and-toxicity/
风险提示:丁香通仅作为第三方平台,为商家信息发布提供平台空间。用户咨询产品时请注意保护个人信息及财产安全,合理判断,谨慎选购商品,商家和用户对交易行为负责。对于医疗器械类产品,请先查证核实企业经营资质和医疗器械产品注册证情况。
技术资料暂无技术资料 索取技术资料